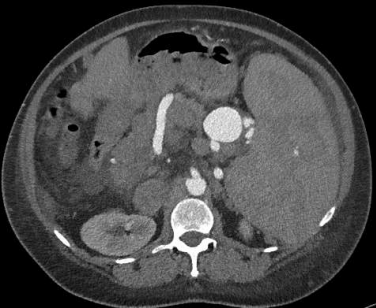

CTA是诊断SAA和其他内脏动脉瘤的理想成像方式。CT在检测小SAAs和评估解剖结构以制定手术计划方面是有用的。磁共振成像(MRI)是一种替代CT,特别是在慢性肾功能不全患者。对比血管造影(CA)是最具体的影像学检查,以确定SAAs,也可能是治疗。内镜超声可以可靠地将SAAs与其他外源性病变如胰腺假性囊肿区分开来。【Fang G 2018;M Özdemir 2017】 无症状患者通常因其它原因在影像学检查查中,包括X线,US]、CT、MRI中偶然发现脾动脉瘤
多排螺旋CT增强扫描是诊断SAA和其他内脏动脉瘤的理想影像学检查方法。CT有助于发现小SAAs并评估解剖结构,为手术规划提供依据。
磁共振成像(MRI)是CT的替代方法,尤其是在慢性肾功能不全患者中。 对比血管造影(Contrast angiography, CA)是识别SAAs最特异的影像学检查,也可能具有治疗作用。 超声内镜可以可靠地鉴别SAAs与胰腺假性囊肿等其他外源性病变 | ||||||||